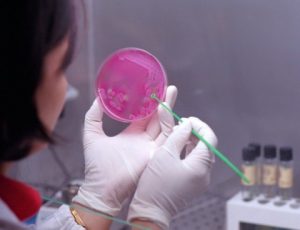

CHIESA CATTOLICA ITALIANA
- Apostolato del mare
- Beni culturali e Edilizia di culto
- Catechistico
- Comunicazioni sociali
- Cooperazione missionaria
- Economato e Amministrazione
- Ecumenismo e dialogo interreligioso
- Educazione, scuola e università
- Insegnamento religione cattolica
- Interventi caritativi sviluppo dei popoli
- Liturgico
- Pastorale della famiglia
- Pastorale della salute
- Pastorale delle persone con disabilità
- Pastorale delle vocazioni
- Pastorale giovanile
- Problemi giuridici
- Problemi sociali e lavoro
- Progetto culturale
- Promozione sostegno economico
- Servizio informatico
- Tempo libero, turismo e sport
- Teologia e scienze religiose
- Tutela dei minori